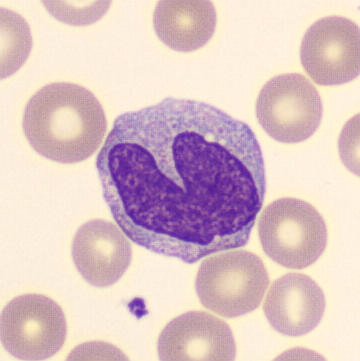
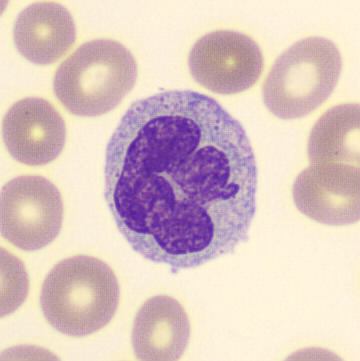
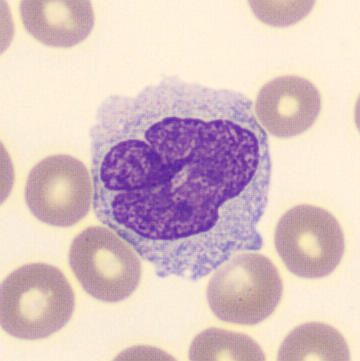
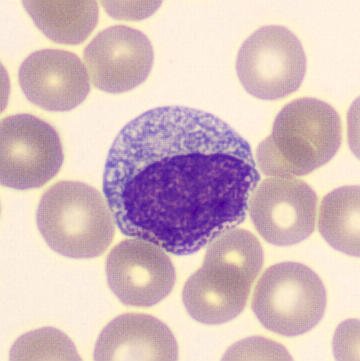

WDF - Monozytose
SFL
SSC
Lymphozyten
Monozyten
Neutrophile
Eosinophile
Basophile
Die stark erhöhte Dichte der Monozytenpopulation weist auf einen starken Anstieg der Monozytenzahl hin. Die abweichende Richtung sowohl in der unteren SFL als auch in der oberen SFL sind starke Indikatoren für eine bösartige Zellpopulation mit dysplastischen oder blastenartigen Monozyten.
Mögliche Morphologie